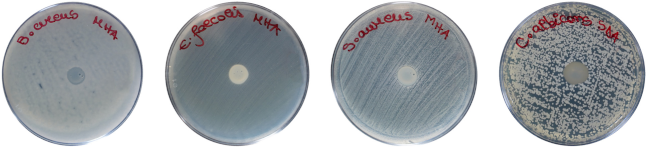
Pharmaceuticals 17 00023 i001

Cytocompatibility, Antimicrobial and Antioxidant Activity of a Mucoadhesive Biopolymeric Hydrogel Embedding Selenium Nanoparticles Phytosynthesized by Sea Buckthorn Leaf Extract
Abstract
:1. Introduction
2. Results
2.1. Phenolic Profile of SbLEx
| Sea Buckthorn Leaf Aqueous Extract (SbLEx) | ||||||
|---|---|---|---|---|---|---|
| TPC (mg GAE */g Dry Weight) | TFC (mg QE */g Dry Weight) | HAT (mg ChAE */g Dry Weight) | TAC (mg C3GE */g Dry Weight) | DPPH (mM TE */g Dry Weight) | FRAP (mM TE/g Dry Weight) | CUPRAC (mM TE/g Dry Weight) |
| 46.59 ± 0.93 | 4.23 ± 0.09 | 11.53 ± 0.23 | 0.0048 ± 0.0002 | 14.75 ± 0.20 | 258.2 ± 1.96 | 1196 ± 7.01 |
| [M + H]+ m/z | Compound | mg Polyphenols × kg−1 of Dry Weight ± Standard Deviation (SD) |
|---|---|---|
| 104.1 | γ-Aminobutyric acid | |
| 193.9 | Quinic acid | |
| 235.0 | Cirsium aldehyde | |
| 266.1 | Thiamine | |
| 291.2 | Catechin (C)/Epicatechin (EC) | 247.52 ± 7.38 for C/35.60 ± 0.920 for EC |
| 449.3 | Quercitrin/Quercetin-7-rhamnoside/Astragalin | |
| 611.3 | Quercetin 3-rutinoside (Que-rut) | 337.06 ± 9.20 for Que-rut |
| 625.2 | Isorhamnetin-3-O-rutinoside/Isorhamnetin-3-O-glucoside/Isorhamnetin-3-O-glucoside-7-O-rhamnoside | |
| 899.3 | Prodelphinidin trimer | |
| 949.3 | Quercetin 3-O-(6-O-feruloylglucoside)-glucoside-7-O-rhamnoside |
2.2. Physicochemical Characterisation of SbLEx and SeNPsSb
| Mean Diameter (nm) | Intensity (%) | Volume (%) | Number (%) |
|---|---|---|---|
| 4.28 | - | - | 100 |
| 104.81 | - | 97.32 | - |
| 142.71 | 24.98 | - | - |
| 514.29 | - | 2.68 | - |
| 657.6 | 75.02 | - | - |
2.3. Biological Performance of SeNPsSb and Se-HNF
| Strain | B. cereus | E. faecalis | S. aureus | C. albicans |
|---|---|---|---|---|
| 2.5 Se-HNF * | 0.740 ± 0.003 | 0.760 ± 0.003 | 0.790 ± 0.010 | 0.810 ± 0.010 |
![]() | ||||
2.4. Physicochemical Characterization of Se-HNF
3. Discussion
4. Materials and Methods
4.1. Materials
4.2. Phytosynthesis of SeNPs with Sea Buckthorn Leaves Aqueous Extract (SbLEx)
4.2.1. Determination of Se Conversion Yield (%)
4.3. Hydrogel Preparation
4.4. Physicochemical Characterisation
4.4.1. Determination of Total Polyphenol Content (TPC) of SbLEx
4.4.2. Total Flavonoid Content (TFC) Measurement of SbLEx
4.4.3. Assessment of Total Hydroxycinnamic Acid Content (HAT) of SbLEx
4.4.4. Quantification of Total Anthocyanins Content (TAC) of SbLEx
4.4.5. Liquid Chromatography–Time-of-Flight/Mass Spectrometry Analysis (LC-TOF/MS) of SbLEx
4.4.6. High-Performance Liquid Chromatography (HPLC-DAD) Analysis of SbLEx
4.4.7. Evaluation of Antioxidant Activity
4.4.8. Fourier Transform Infrared Spectroscopy (FTIR) Analysis
4.4.9. X-ray Diffraction (XRD) Analysis
4.4.10. Transmission Electron Microscopy (TEM)–Energy Dispersive X-ray (EDX) Analysis
4.4.11. Dynamic Light Scattering (DLS) and Zeta Potential Analysis
4.4.12. Measurement of Mucin Binding Efficiency
4.4.13. Scanning Electron Microscopy (SEM)
4.4.14. Contact Angle and Interfacial Tension Measurements
4.4.15. Rheological Analysis
4.5. Assessement of In Vitro Biocompatibility of SeNPsSb and Se-HNF
4.6. Determination of In Vitro Antioxidant Activity of SeNPsSb and Se-HNF
4.7. Investigation of Antimicrobial and Antibiofilm Activity of SeNPsSb, and Se-HNF
5. Conclusions
Supplementary Materials
Author Contributions
Funding
Institutional Review Board Statement
Informed Consent Statement
Data Availability Statement
Acknowledgments
Conflicts of Interest
References
- Donkor, E.A.-O.; Kotey, F.C. Methicillin-Resistant Staphylococcus aureus in the Oral Cavity: Implications for Antibiotic Prophylaxis and Surveillance. Infect. Dis. 2020, 13, 1178633720976581. [Google Scholar] [CrossRef] [PubMed]
- Murakami, S.; Mealey, B.L.; Mariotti, A.; Chapple, I.L.C. Dental plaque–induced gingival conditions. J. Periodontol. 2018, 89, S17–S27. [Google Scholar] [CrossRef] [PubMed]
- Meyle, J.; Chapple, I. Molecular aspects of the pathogenesis of periodontitis. Periodontology 2015, 69, 7–17. [Google Scholar] [CrossRef] [PubMed]
- Lang, N.; Bartold, P. Periodontal health. J. Clin. Periodontol. 2018, 45, S9–S16. [Google Scholar] [CrossRef] [PubMed]
- Kinane, D.F. Periodontitis Modified by Systemic Factors. Ann. Periodontol. 1999, 4, 54–63. [Google Scholar] [CrossRef] [PubMed]
- Parham, S.; Kharazi, A.Z.; Bakhsheshi-Rad, H.R.; Nur, H.; Ismail, A.F.; Sharif, S.; RamaKrishna, S.; Berto, F. Antioxidant, Antimicrobial and Antiviral Properties of Herbal Materials. Antioxidants 2020, 9, 1309. [Google Scholar] [CrossRef] [PubMed]
- Upadhyay, N.K.; Yogendra Kumar, M.S.; Gupta, A. Antioxidant, cytoprotective and antibacterial effects of Sea buckthorn (Hippophae rhamnoides L.) leaves. Food Chem. Toxicol. 2010, 48, 3443–3448. [Google Scholar] [CrossRef] [PubMed]
- Ganju, L.; Padwad, Y.; Singh, R.; Karan, D.; Chanda, S.; Chopra, M.K.; Bhatnagar, P.; Kashyap, R.; Sawhney, R.C. Anti-inflammatory activity of Seabuckthorn (Hippophae rhamnoides) leaves. Int. Immunopharmacol. 2005, 5, 1675–1684. [Google Scholar] [CrossRef]
- Enkhtaivan, G.; Maria John, K.M.; Pandurangan, M.; Hur, J.H.; Leutou, A.S.; Kim, D.H. Extreme effects of Seabuckthorn extracts on influenza viruses and human cancer cells and correlation between flavonol glycosides and biological activities of extracts. Saudi J. Biol. Sci. 2017, 24, 1646–1656. [Google Scholar] [CrossRef]
- Maseko, T.; Callahan, D.L.; Dunshea, F.R.; Doronila, A.; Kolev, S.D.; Ng, K. Chemical characterisation and speciation of organic selenium in cultivated selenium-enriched Agaricus bisporus. Food Chem. 2013, 141, 3681–3687. [Google Scholar] [CrossRef]
- Oldfield, J.E. The two faces of selenium. J. Nutr. 1987, 117, 2002–2008. [Google Scholar] [CrossRef] [PubMed]
- Alam, H.; Khatoon, N.; Khan, M.A.; Husain, S.A.; Saravanan, M.; Sardar, M. Synthesis of Selenium Nanoparticles Using Probiotic Bacteria Lactobacillus acidophilus and Their Enhanced Antimicrobial Activity Against Resistant Bacteria. J. Clust. Sci. 2020, 31, 1003–1011. [Google Scholar] [CrossRef]
- Cittrarasu, V.; Kaliannan, D.; Dharman, K.; Maluventhen, V.; Easwaran, M.; Liu, W.C.; Balasubramanian, B.; Arumugam, M. Green synthesis of selenium nanoparticles mediated from Ceropegia bulbosa Roxb extract and its cytotoxicity, antimicrobial, mosquitocidal and photocatalytic activities. Sci. Rep. 2021, 11, 1032. [Google Scholar] [CrossRef] [PubMed]
- Escobar-Ramírez, M.C.; Castañeda-Ovando, A.; Pérez-Escalante, E.; Rodríguez-Serrano, G.M.; Ramírez-Moreno, E.; Quintero-Lira, A.; Contreras-López, E.; Añorve-Morga, J.; Jaimez-Ordaz, J.; González-Olivares, L.G. Antimicrobial Activity of Se-Nanoparticles from Bacterial Biotransformation. Fermentation 2021, 7, 130. [Google Scholar] [CrossRef]
- Huang, X.; Chen, X.; Chen, Q.; Yu, Q.; Sun, D.; Liu, J. Investigation of functional selenium nanoparticles as potent antimicrobial agents against superbugs. Acta Biomater. 2016, 30, 397–407. [Google Scholar] [CrossRef]
- Zhang, H.; Li, Z.; Dai, C.; Wang, P.; Fan, S.; Yu, B.; Qu, Y. Antibacterial properties and mechanism of selenium nanoparticles synthesized by Providencia sp. DCX. Environ. Res. 2021, 194, 110630. [Google Scholar] [CrossRef]
- Zonaro, E.; Lampis, S.; Turner, R.J.; Qazi, S.J.S.; Vallini, G. Biogenic selenium and tellurium nanoparticles synthesized by environmental microbial isolates efficaciously inhibit bacterial planktonic cultures and biofilms. Front. Microbiol. 2015, 6, 584. [Google Scholar] [CrossRef]
- Dima, S.-O.; Panaitescu, D.-M.; Orban, C.; Ghiurea, M.; Doncea, S.-M.; Fierascu, R.C.; Nistor, C.L.; Alexandrescu, E.; Nicolae, C.-A.; Trică, B.; et al. Bacterial Nanocellulose from Side-Streams of Kombucha Beverages Production: Preparation and Physical-Chemical Properties. Polymers 2017, 9, 374. [Google Scholar] [CrossRef]
- de Amorim, J.D.P.; de Souza, K.C.; Duarte, C.R.; da Silva Duarte, I.; de Assis Sales Ribeiro, F.; Silva, G.S.; de Farias, P.M.A.; Stingl, A.; Costa, A.F.S.; Vinhas, G.M.; et al. Plant and bacterial nanocellulose: Production, properties and applications in medicine, food, cosmetics, electronics and engineering. A review. Environ. Chem. Lett. 2020, 18, 851–869. [Google Scholar] [CrossRef]
- Li, J.; Cha, R.; Mou, K.; Zhao, X.; Long, K.; Luo, H.; Zhou, F.; Jiang, X. Nanocellulose-Based Antibacterial Materials. Adv. Healthc. Mater. 2018, 7, 1800334. [Google Scholar] [CrossRef]
- Parry, A. Nanocellulose and its Composites for Biomedical Applications. Curr. Med. Chem. 2016, 23, 512–528. [Google Scholar] [CrossRef]
- Ahmed, S.; Ikram, S. Chitosan Based Scaffolds and Their Applications in Wound Healing. Achiev. Life Sci. 2016, 10, 27–37. [Google Scholar] [CrossRef]
- Dai, T.; Tanaka, M.; Huang, Y.-Y.; Hamblin, M.R. Chitosan preparations for wounds and burns: Antimicrobial and wound-healing effects. Expert Rev. Anti-Infect. Ther. 2011, 9, 857–879. [Google Scholar] [CrossRef] [PubMed]
- Liu, Y.; Chen, J.; Li, P.; Ning, N. The Effect of Chitosan in Wound Healing: A Systematic Review. Adv. Ski. Wound Care 2021, 34, 262–266. [Google Scholar] [CrossRef] [PubMed]
- Matica, M.A.; Aachmann, F.L.; Tøndervik, A.; Sletta, H.; Ostafe, V. Chitosan as a Wound Dressing Starting Material: Antimicrobial Properties and Mode of Action. Int. J. Mol. Sci. 2019, 20, 5889. [Google Scholar] [CrossRef] [PubMed]
- Khan, A.; Wang, B.; Ni, Y. Chitosan-Nanocellulose Composites for Regenerative Medicine Applications. Curr. Med. Chem. 2020, 27, 4584–4592. [Google Scholar] [CrossRef] [PubMed]
- Tritean, N.; Dima, Ș.-O.; Trică, B.; Stoica, R.; Ghiurea, M.; Moraru, I.; Cimpean, A.; Oancea, F.; Constantinescu-Aruxandei, D. Selenium-Fortified Kombucha–Pollen Beverage by In Situ Biosynthesized Selenium Nanoparticles with High Biocompatibility and Antioxidant Activity. Antioxidants 2023, 12, 1711. [Google Scholar] [CrossRef] [PubMed]
- Jia, X.W.; Liu, Q.; Zou, S.; Xu, X.; Zhang, L. Construction of selenium nanoparticles/beta-glucan composites for enhancement of the antitumor activity. Carbohydr. Polym. 2015, 117, 434–442. [Google Scholar] [CrossRef]
- Reddy, J.R.S.M.; Kannan, K.P.; Sankaran, K.; Rengasamy, G.; Priya, V.V.; Sathishkumar, P. Eradication of dental pathogens using flavonoid rutin mediated silver-selenium nanoparticles. Inorg. Chem. Commun. 2023, 157, 434–442. [Google Scholar] [CrossRef]
- Manaa, H.M.; Hamza, E.M.; Sorour, N.M. Post-harvest biocontrol of Fusarium infection in tomato fruits using bio-mediated selenium nanoparticles. AMB Express 2023, 13, 18. [Google Scholar] [CrossRef]
- Velayati, M.; Hassani, H.; Hosseini, H.A.; Sabouri, Z.; Mostafapour, A.; Darroudi, M. Xanthan gum-mediated green synthesis of Se-nanoparticles for evaluation of photocatalytic and cytotoxicity effects. Eur. Phys. J. Plus 2023, 138, 18. [Google Scholar] [CrossRef]
- Prasad, K.S.; Patel, H.; Patel, T.; Patel, K.; Selvaraj, K. Biosynthesis of Se nanoparticles and its effect on UV-induced DNA damage. Colloids Surf. B Biointerfaces 2013, 103, 261–266. [Google Scholar] [CrossRef] [PubMed]
- Chen, W.; Li, X.; Cheng, H.; Zhan, X.; Xia, W. Synthesis, characterization, and anticancer activity of protamine sulfate stabilized selenium nanoparticles. Food Res. Int. 2023, 164, 112435. [Google Scholar] [CrossRef] [PubMed]
- Ayad, M.M.; Torad, N.L.; Abu El-Nasr, A.; Amer, W.A. Study on catalytic efficiency of platinum and silver nanoparticles confined in nanosized channels of a 3-D mesostructured silica. J. Porous Mater. 2021, 28, 65–79. [Google Scholar] [CrossRef]
- Nagahama, H.; Maeda, H.; Kashiki, T.; Jayakumar, R.; Furuike, T.; Tamura, H. Preparation and characterization of novel chitosan/gelatin membranes using chitosan hydrogel. Carbohydr. Polym. 2009, 76, 255–260. [Google Scholar] [CrossRef]
- Yao, J.F.; Chen, R.; Wang, K.; Wang, H. Direct synthesis of zeolitic imidazolate framework-8/chitosan composites in chitosan hydrogels. Microporous Mesoporous Mater. 2013, 165, 200–204. [Google Scholar] [CrossRef]
- Jiang, M.; Wang, K.; Kennedy, J.F.; Nie, J.; Yu, Q.; Ma, G. Preparation and characterization of water-soluble chitosan derivative by Michael addition reaction. Int. J. Biol. Macromol. 2010, 47, 696–699. [Google Scholar] [CrossRef] [PubMed]
- Chen, T. Rheology: Basic Theory and Applications Training. Available online: https://www.tainstruments.com/wp-content/uploads/2020-Rheology-Online-Training-2.pdf (accessed on 27 September 2023).
- Barl, B.; Akhov, L.; Dunlop, D.; Jana, S.; Schroeder, W. Flavonoid content and composition in leaves and berries of sea buckthorn (Hippophae spp.) of different origin. Acta Hortic. 2003, 626, 397–405. [Google Scholar] [CrossRef]
- Raudone, L.; Januskevice, V.; Vilkickytė, G.; Niekyte, A.; Lanauskas, J.; Viškelis, J.; Viskelis, P. Sea Buckthorn Leaf Powders: The Impact of Cultivar and Drying Mode on Antioxidant, Phytochemical, and Chromatic Profile of Valuable Resource. Molecules 2021, 26, 4765. [Google Scholar] [CrossRef]
- Pariyani, R.; Kortesniemi, M.; Liimatainen, J.; Sinkkonen, J.; Yang, B. Untargeted metabolic fingerprinting reveals impact of growth stage and location on composition of sea buckthorn (Hippophaë rhamnoides) leaves. J. Food Sci. 2020, 85, 364–373. [Google Scholar] [CrossRef]
- Wang, N.; Wen, X.; Gao, Y.; Lu, S.; Li, Y.; Shi, Y.; Yang, Z. Identification and Characterization of the Bioactive Polyphenols and Volatile Compounds in Sea Buckthorn Leaves Tea Together With Antioxidant and α-Glucosidase Inhibitory Activities. Front. Nutr. 2022, 9, 890486. [Google Scholar] [CrossRef] [PubMed]
- Heikkilä, E.; Hermant, A.; Thevenet, J.; Bermont, F.; Kulkarni, S.S.; Ratajczak, J.; Santo-Domingo, J.; Dioum, E.H.; Canto, C.; Barron, D.; et al. The plant product quinic acid activates Ca2+-dependent mitochondrial function and promotes insulin secretion from pancreatic beta cells. Br. J. Pharmacol. 2019, 176, 3250–3263. [Google Scholar] [CrossRef] [PubMed]
- Wang, Z.; Li, X.; Zhen, S.; Li, X.; Wang, C.; Wang, Y. The important role of quinic acid in the formation of phenolic compounds from pyrolysis of chlorogenic acid. J. Therm. Anal. Calorim. 2013, 114, 1231–1238. [Google Scholar] [CrossRef]
- Pundir, S.; Garg, P.; Dviwedi, A.; Ali, A.; Kapoor, V.K.; Kapoor, D.; Kulshrestha, S.; Lal, U.R.; Negi, P. Ethnomedicinal uses, phytochemistry and dermatological effects of Hippophae rhamnoides L.: A review. J. Ethnopharmacol. 2021, 266, 113434. [Google Scholar] [CrossRef] [PubMed]
- He, Q.; Yang, K.; Wu, X.; Zhang, C.; He, C.A.-O.; Xiao, P. Phenolic compounds, antioxidant activity and sensory evaluation of sea buckthorn (Hippophae rhamnoides L.) leaf tea. Food Sci. Nutr. 2022, 11, 1212–1222. [Google Scholar] [CrossRef]
- Septembre-Malaterre, A.; Boumendjel, A.; Seteyen, A.-L.S.; Boina, C.; Gasque, P.; Guiraud, P.; Sélambarom, J. Focus on the high therapeutic potentials of quercetin and its derivatives. Phytomed. Plus 2022, 2, 100220. [Google Scholar] [CrossRef]
- Jan, R.; Khan, M.; Asaf, S.; Lubna; Asif, S.; Kim, K.-M. Bioactivity and Therapeutic Potential of Kaempferol and Quercetin: New Insights for Plant and Human Health. Plants 2022, 11, 2623. [Google Scholar] [CrossRef]
- Riaz, A.; Rasul, A.A.-O.; Hussain, G.; Zahoor, M.A.-O.; Jabeen, F.; Subhani, Z.; Younis, T.; Ali, M.; Sarfraz, I.; Selamoglu, Z. Astragalin: A Bioactive Phytochemical with Potential Therapeutic Activities. Adv. Pharmacol. Sci. 2018, 2018, 9794625. [Google Scholar] [CrossRef]
- Wang, Z.; Zhao, F.; Wei, P.; Chai, X.; Hou, G.; Meng, Q. Phytochemistry, health benefits, and food applications of sea buckthorn (Hippophae rhamnoides L.): A comprehensive review. Front. Nutr. 2022, 9, 1036295. [Google Scholar] [CrossRef]
- Kallio, H.; Yang, W.; Liu, P.; Yang, B. Proanthocyanidins in Wild Sea Buckthorn (Hippophae rhamnoides) Berries Analyzed by Reversed-Phase, Normal-Phase, and Hydrophilic Interaction Liquid Chromatography with UV and MS Detection. J. Agric. Food Chem. 2014, 62, 7721–7729. [Google Scholar] [CrossRef]
- Tian, Y.; Liimatainen, J.; Alanne, A.-L.; Lindstedt, A.; Liu, P.; Sinkkonen, J.; Kallio, H.; Yang, B. Phenolic compounds extracted by acidic aqueous ethanol from berries and leaves of different berry plants. Food Chem. 2017, 220, 266–281. [Google Scholar] [CrossRef] [PubMed]
- Sytařová, I.; Orsavová, J.; Snopek, L.; Mlček, J.; Byczyński, Ł.; Mišurcová, L. Impact of phenolic compounds and vitamins C and E on antioxidant activity of sea buckthorn (Hippophaë rhamnoides L.) berries and leaves of diverse ripening times. Food Chem. 2020, 310, 125784. [Google Scholar] [CrossRef] [PubMed]
- Bittová, M.; Krejzová, E.; Roblova, V.; Kubáň, P.; Kubáň, V. Monitoring of HPLC profiles of selected polyphenolic compounds in sea buckthorn (HippophaA rhamnoides L.) plant parts during annual growth cycle and estimation of their antioxidant potential. Cent. Eur. J. Chem. 2014, 12, 1152–1161. [Google Scholar] [CrossRef]
- Zu, Y.; Li, C.; Fu, Y.; Zhao, C. Simultaneous determination of catechin, rutin, quercetin kaempferol and isorhamnetin in the extract of sea buckthorn (Hippophae rhamnoides L.) leaves by RP-HPLC with DAD. J. Pharm. Biomed. Anal. 2006, 41, 714–719. [Google Scholar] [CrossRef] [PubMed]
- Abdelhamid, A.E.; Ahmed, E.H.; Awad, H.M.; Ayoub, M.M.H. Synthesis and cytotoxic activities of selenium nanoparticles incorporated nano-chitosan. Polym. Bull. 2023, 1–17. [Google Scholar] [CrossRef]
- Abu-Elghait, M.; Hasanin, M.; Hashem, A.H.; Salem, S.S. Ecofriendly novel synthesis of tertiary composite based on cellulose and myco-synthesized selenium nanoparticles: Characterization, antibiofilm and biocompatibility. Int. J. Biol. Macromol. 2021, 175, 294–303. [Google Scholar] [CrossRef] [PubMed]
- Hariharan, S.; Chauhan, S.; Velu, K.; Dharmaraj, S.; C M, V.K.; Ganesan, S. Biological Activities of Selenium Nanoparticles Synthesized from Camellia sinensis (L) Kuntze Leaves. Appl. Biochem. Biotechnol. 2023, 195, 5823–5837. [Google Scholar] [CrossRef]
- Lazcano-Ramírez, H.G.; Garza-García, J.J.O.; Hernández-Díaz, J.A.; León-Morales, J.M.; Macías-Sandoval, A.S.; García-Morales, S. Antifungal Activity of Selenium Nanoparticles Obtained by Plant-Mediated Synthesis. Antibiotics 2023, 12, 115. [Google Scholar] [CrossRef]
- Martínez-Esquivias, F.; Guzmán-Flores, J.M.; Perez-Larios, A. Antimicrobial activity of green synthesized Se nanoparticles using ginger and onion extract: A laboratory and in silico analysis. Part. Sci. Technol. 2022, 41, 319–329. [Google Scholar] [CrossRef]
- Sentkowska, A.; Pyrzyńska, K. The Influence of Synthesis Conditions on the Antioxidant Activity of Selenium Nanoparticles. Molecules 2022, 27, 2486. [Google Scholar] [CrossRef]
- Sowndarya, P.; Ramkumar, G.; Shivakumar, M.S. Green synthesis of selenium nanoparticles conjugated Clausena dentata plant leaf extract and their insecticidal potential against mosquito vectors. Artif. Cells Nanomed. Biotechnol. 2017, 45, 1490–1495. [Google Scholar] [CrossRef] [PubMed]
- Ramamurthy, C.H.; Sampath, K.S.; Arunkumar, P.; Kumar, M.S.; Sujatha, V.; Premkumar, K.; Thirunavukkarasu, C. Green synthesis and characterization of selenium nanoparticles and its augmented cytotoxicity with doxorubicin on cancer cells. Bioprocess Biosyst. Eng. 2013, 36, 1131–1139. [Google Scholar] [CrossRef] [PubMed]
- Prasad, K.S.; Selvaraj, K. Biogenic Synthesis of Selenium Nanoparticles and Their Effect on As(III)-Induced Toxicity on Human Lymphocytes. Biol. Trace Elem. Res. 2014, 157, 275–283. [Google Scholar] [CrossRef] [PubMed]
- Alam, H.; Khatoon, N.; Raza, M.; Ghosh, P.C.; Sardar, M. Synthesis and Characterization of Nano Selenium Using Plant Biomolecules and Their Potential Applications. BioNanoScience 2019, 9, 96–104. [Google Scholar] [CrossRef]
- Sharma, G.; Sharma, A.R.; Bhavesh, R.; Park, J.; Ganbold, B.; Nam, J.-S.; Lee, S.-S. Biomolecule-Mediated Synthesis of Selenium Nanoparticles using Dried Vitis vinifera (Raisin) Extract. Molecules 2014, 19, 2761–2770. [Google Scholar] [CrossRef] [PubMed]
- Li, S.; Shen, Y.; Xie, A.; Yu, X.; Zhang, X.; Yang, L.; Li, C. Rapid, room-temperature synthesis of amorphous selenium/protein composites using Capsicum annuum L extract. Nanotechnology 2007, 18, 405101. [Google Scholar] [CrossRef]
- Tuyen, N.N.K.; Huong, Q.T.T.; Nam, N.T.H.; Hai, N.D.; Tinh, N.T.; Buu, T.T.; Le Hoai Nhi, T.; Duy, B.T.; Khanh, T.N.; Nhiem, L.T.; et al. Applicable orientation of eco-friendly phyto-synthesized selenium nanoparticles: Bioactive investigation and dye photodegradation. Biomass Convers. Biorefin. 2023. [Google Scholar] [CrossRef]
- Paster Bruce, J.; Boches Susan, K.; Galvin Jamie, L.; Ericson Rebecca, E.; Lau Carol, N.; Levanos Valerie, A.; Sahasrabudhe, A.; Dewhirst Floyd, E. Bacterial Diversity in Human Subgingival Plaque. J. Bacteriol. 2001, 183, 3770–3783. [Google Scholar] [CrossRef]
- Mulani, M.S.; Kamble, E.E.; Kumkar, S.N.; Tawre, M.S.; Pardesi, K.R. Emerging Strategies to Combat ESKAPE Pathogens in the Era of Antimicrobial Resistance: A Review. Front. Microbiol. 2019, 10, 539. [Google Scholar] [CrossRef]
- Helgason, E.; Caugant Dominique, A.; Olsen, I.; Kolstø, A.-B. Genetic Structure of Population of Bacillus cereus and B. thuringiensis Isolates Associated with Periodontitis and Other Human Infections. J. Clin. Microbiol. 2000, 38, 1615–1622. [Google Scholar] [CrossRef]
- Chidambar, C.K.; Shankar, S.M.; Raghu, P.; Gururaj, S.B.; Bushan, K.S. Detection of Enterococcus faecalis in subgingival biofilms of healthy, gingivitis, and chronic periodontitis subjects. J. Indian Soc. Periodontol. 2019, 23, 416–418. [Google Scholar] [CrossRef] [PubMed]
- Rams, T.E.; Feik, D.; Slots, J. Staphylococci in human periodontal diseases. Oral Microbiol. Immunol. 1990, 5, 29–32. [Google Scholar] [CrossRef] [PubMed]
- Barchielli, G.; Capperucci, A.; Tanini, D. The Role of Selenium in Pathologies: An Updated Review. Antioxidants 2022, 11, 251. [Google Scholar] [CrossRef] [PubMed]
- Yuan, Q.; Xiao, R.; Afolabi, M.; Bomma, M.; Xiao, Z. Evaluation of Antibacterial Activity of Selenium Nanoparticles against Food-Borne Pathogens. Microorganisms 2023, 11, 1519. [Google Scholar] [CrossRef] [PubMed]
- Jabri, B.A.-O.; Iken, M.A.-O.; Ait-Ou-Amar, S.A.-O.; Rida, S.A.-O.; Bouziane, A.A.-O.; Ennibi, O.A.-O. Candida albicans and Candida dubliniensis in Periodontitis in Adolescents and Young Adults. Int. J. Microbiol. 2022, 2022, 4625368. [Google Scholar] [CrossRef]
- Suresh Unniachan, A.; Krishnavilasom Jayakumari, N.; Sethuraman, S. Association between Candida species and periodontal disease: A systematic review. Curr. Med. Mycol. 2020, 6, 63–68. [Google Scholar] [CrossRef] [PubMed]
- Roblegg, E.; Coughran, A.; Sirjani, D. Saliva: An all-rounder of our body. Eur. J. Pharm. Biopharm. 2019, 142, 133–141. [Google Scholar] [CrossRef]
- Sánchez, G.A.; Miozza, V.; Delgado, A.; Busch, L. Determination of salivary levels of mucin and amylase in chronic periodontitis patients. J. Periodontal Res. 2011, 46, 221–227. [Google Scholar] [CrossRef]
- Sogias, I.A.; Williams, A.C.; Khutoryanskiy, V.V. Why is Chitosan Mucoadhesive? Biomacromolecules 2008, 9, 1837–1842. [Google Scholar] [CrossRef]
- Han, B.; Cao, C.L.; Wang, A.J.; Zhao, Y.R.; Jin, M.R.; Wang, Y.H.; Chen, S.Q.; Yu, M.; Yang, Z.Z.; Qu, X.Z.; et al. Injectable Double-Network Hydrogel-Based Three-Dimensional Cell Culture Systems for Regenerating Dental Pulp. ACS Appl. Mater. Interfaces 2023, 12, 7821–7832. [Google Scholar] [CrossRef]
- Moraru, A.; Dima, O.; Tritean, N.; Oprița, E.-I.; Prelipcean, A.-M.; Trică, B.; Oancea, A.; Moraru, I.; Constantinescu-Aruxandei, D.; Oancea, F. Bioactive-Loaded Hydrogels Based on Bacterial Nanocellulose, Chitosan, and Poloxamer for Rebalancing Vaginal Microbiota. Pharmaceuticals 2023, 16, 1671. [Google Scholar] [CrossRef] [PubMed]
- Baixe, S.; Ball, V.; Jierry, L.; Cianferani, S.; Strub, J.M.; Haikel, Y.; Metz-Boutigue, M.H.; Etienne, O. Strongly Adhesive and Antimicrobial Peptide-Loaded, Alginate-Catechol-Based Gels for Application against Periimplantitis. Appl. Sci. 2021, 11, 10050. [Google Scholar] [CrossRef]
- Biswas, K.C.; Barton, L.L.; Tsui, W.L.; Shuman, K.; Gillespie, J.; Eze, C.S. A novel method for the measurement of elemental selenium produced by bacterial reduction of selenite. J. Microbiol. Methods 2011, 86, 140–144. [Google Scholar] [CrossRef] [PubMed]
- Singleton, V.L.; Orthofer, R.; Lamuela-Raventós, R.M. [14] Analysis of total phenols and other oxidation substrates and antioxidants by means of folin-ciocalteu reagent. In Methods in Enzymology; Academic Press: Cambridge, MA, USA, 1999; Volume 299, pp. 152–178. [Google Scholar]
- Dimitriu, L.; Constantinescu-Aruxandei, D.; Preda, D.; Nichițean, A.-L.; Nicolae, C.-A.; Faraon, V.A.; Ghiurea, M.; Ganciarov, M.; Băbeanu, N.E.; Oancea, F. Honey and Its Biomimetic Deep Eutectic Solvent Modulate the Antioxidant Activity of Polyphenols. Antioxidants 2022, 11, 2194. [Google Scholar] [CrossRef] [PubMed]
- Uțoiu, E.; Matei, F.; Toma, A.; Diguță, C.F.; Ștefan, L.M.; Mănoiu, S.; Vrăjmașu, V.V.; Moraru, I.; Oancea, A.; Israel-Roming, F.; et al. Bee Collected Pollen with Enhanced Health Benefits, Produced by Fermentation with a Kombucha Consortium. Nutrients 2018, 10, 1365. [Google Scholar] [CrossRef] [PubMed]
- Stoica, R.; Senin, R.; Ion, R.-M. Ethanol Concentration Effect on the Extraction of Phenolic Compounds from Ribes nigrum. Assessed by Spectrophotometric and HPLC-DAD Methods. Rev. Chim.-Buchar.-Orig. Ed. 2013, 64, 620–624. [Google Scholar]
- Apak, R.; Özyürek, M.; Güçlü, K.; Bekdeşer, B.; Bener, M. Chapter 24—The CUPRAC Methods of Antioxidant Measurement for Beverages. In Processing and Impact on Antioxidants in Beverages; Preedy, V., Ed.; Academic Press: San Diego, CA, USA, 2014; pp. 235–244. [Google Scholar]
- Li, T.; Senesi, A.J.; Lee, B. Small Angle X-ray Scattering for Nanoparticle Research. Chem. Rev. 2016, 116, 11128–11180. [Google Scholar] [CrossRef] [PubMed]
- Gommes, C.J.; Jaksch, S.; Frielinghaus, H. Small-angle scattering for beginners. J. Appl. Crystallogr. 2021, 54, 1832–1843. [Google Scholar] [CrossRef]
- Mantle, M.; Allen, A. A Colorimetric Assay for Glycoproteins Based on the Periodic Acid/Schiff Stain. Biochem. Soc. Trans. 1978, 6, 607–609. [Google Scholar] [CrossRef]
- Hejjaji, E.; Smith, A.; Morris, G. Evaluation of the mucoadhesive properties of chitosan nanoparticles prepared using different chitosan to tripolyphosphate (CS:TPP) ratios. Int. J. Biol. Macromol. 2018, 120, 1610–1617. [Google Scholar] [CrossRef]
- Kim, H.; Xue, X. Detection of Total Reactive Oxygen Species in Adherent Cells by 2’,7’-Dichlorodihydrofluorescein Diacetate Staining. J. Vis. Exp. 2020, 23. [Google Scholar] [CrossRef]
- Schneider, C.A.; Rasband, W.S.; Eliceiri, K.W. NIH Image to ImageJ: 25 years of image analysis. Nat. Methods 2012, 9, 671–675. [Google Scholar] [CrossRef] [PubMed]
- Filipović, N.; Ušjak, D.; Milenković, M.T.; Zheng, K.; Liverani, L.; Boccaccini, A.R.; Stevanović, M.M. Comparative Study of the Antimicrobial Activity of Selenium Nanoparticles with Different Surface Chemistry and Structure. Front. Bioeng. Biotechnol. 2021, 8, 624621. [Google Scholar] [CrossRef] [PubMed]
- AAT Bioquest. IC50 Calculator. Available online: https://www.aatbio.com/tools/ic50-calculator (accessed on 27 November 2023).










| Average Diameter of the Inhibition Zone (cm) ± Standard Error (SE) | ||||||
|---|---|---|---|---|---|---|
| Concentration (mg/mL) | 0.05 | 0.1 | 0.2 | 0.5 | 1 | 2 |
| B. cereus | * R | * R | * R | 0.84 ± 0.01 a ** | 0.88 ± 0.03 a | 0.87 ± 0.01 a |
| E. faecalis | * R | 0.39 ± 0.001 a | 0.51 ± 0.006 b | 0.86 ± 0.009 c | 0.86 ± 0.02 c | 0.906 ± 0.03 c |
| S. aureus | 0.86 ± 0.01 a | 0.86 ± 0.008 a | 0.89 ± 0.03 a | 0.98 ± 0.03 a | 1.04 ± 0.07 a | 1.02 ± 0.06 a |
| C. albicans | * R | * R | * R | * R | * R | * R |
| Strain | MIC (mg/mL) | IC50 (mg/mL) ± SE | MCEB (mg/mL) | |
|---|---|---|---|---|
| B. cereus | 1.5 | 0.708 ± 0.031 | - | |
| E. faecalis | 1 | 0.039 ± 0.008 | 0.1 | |
| S. aureus | 1 | 0.288 ± 0.004 | - | |
| C. albicans | 0.75 | 0.143 ± 0.001 | - | |
| Bacterial biofilm inhibition ± standard error 24 h after SeNPsSb treatment | ||||
| E. faecalis/ at SeNPsSb (mg/mL) | 81.22 ± 3.93/ 0.05 | 64.19 ± 2.62/ 0.025 | 57.64 ± 3.93/ 0.01 | 36.68 ± 1.31/ 0.005 |
| Contact Angle (°) ± SD | Interfacial Tension (mN/m) ± SD | |
|---|---|---|
| Glass | Polystyrene | |
| 52.82 ± 1.23 | 73.85 ± 0.39 | 97.6 ± 0.47 |
![]() | ||
Disclaimer/Publisher’s Note: The statements, opinions and data contained in all publications are solely those of the individual author(s) and contributor(s) and not of MDPI and/or the editor(s). MDPI and/or the editor(s) disclaim responsibility for any injury to people or property resulting from any ideas, methods, instructions or products referred to in the content. |
© 2023 by the authors. Licensee MDPI, Basel, Switzerland. This article is an open access article distributed under the terms and conditions of the Creative Commons Attribution (CC BY) license (https://creativecommons.org/licenses/by/4.0/).
Share and Cite
Tritean, N.; Dimitriu, L.; Dima, Ș.-O.; Stoica, R.; Trică, B.; Ghiurea, M.; Moraru, I.; Cimpean, A.; Oancea, F.; Constantinescu-Aruxandei, D. Cytocompatibility, Antimicrobial and Antioxidant Activity of a Mucoadhesive Biopolymeric Hydrogel Embedding Selenium Nanoparticles Phytosynthesized by Sea Buckthorn Leaf Extract. Pharmaceuticals 2024, 17, 23. https://doi.org/10.3390/ph17010023
Tritean N, Dimitriu L, Dima Ș-O, Stoica R, Trică B, Ghiurea M, Moraru I, Cimpean A, Oancea F, Constantinescu-Aruxandei D. Cytocompatibility, Antimicrobial and Antioxidant Activity of a Mucoadhesive Biopolymeric Hydrogel Embedding Selenium Nanoparticles Phytosynthesized by Sea Buckthorn Leaf Extract. Pharmaceuticals. 2024; 17(1):23. https://doi.org/10.3390/ph17010023
Chicago/Turabian StyleTritean, Naomi, Luminița Dimitriu, Ștefan-Ovidiu Dima, Rusăndica Stoica, Bogdan Trică, Marius Ghiurea, Ionuț Moraru, Anisoara Cimpean, Florin Oancea, and Diana Constantinescu-Aruxandei. 2024. "Cytocompatibility, Antimicrobial and Antioxidant Activity of a Mucoadhesive Biopolymeric Hydrogel Embedding Selenium Nanoparticles Phytosynthesized by Sea Buckthorn Leaf Extract" Pharmaceuticals 17, no. 1: 23. https://doi.org/10.3390/ph17010023
APA StyleTritean, N., Dimitriu, L., Dima, Ș.-O., Stoica, R., Trică, B., Ghiurea, M., Moraru, I., Cimpean, A., Oancea, F., & Constantinescu-Aruxandei, D. (2024). Cytocompatibility, Antimicrobial and Antioxidant Activity of a Mucoadhesive Biopolymeric Hydrogel Embedding Selenium Nanoparticles Phytosynthesized by Sea Buckthorn Leaf Extract. Pharmaceuticals, 17(1), 23. https://doi.org/10.3390/ph17010023